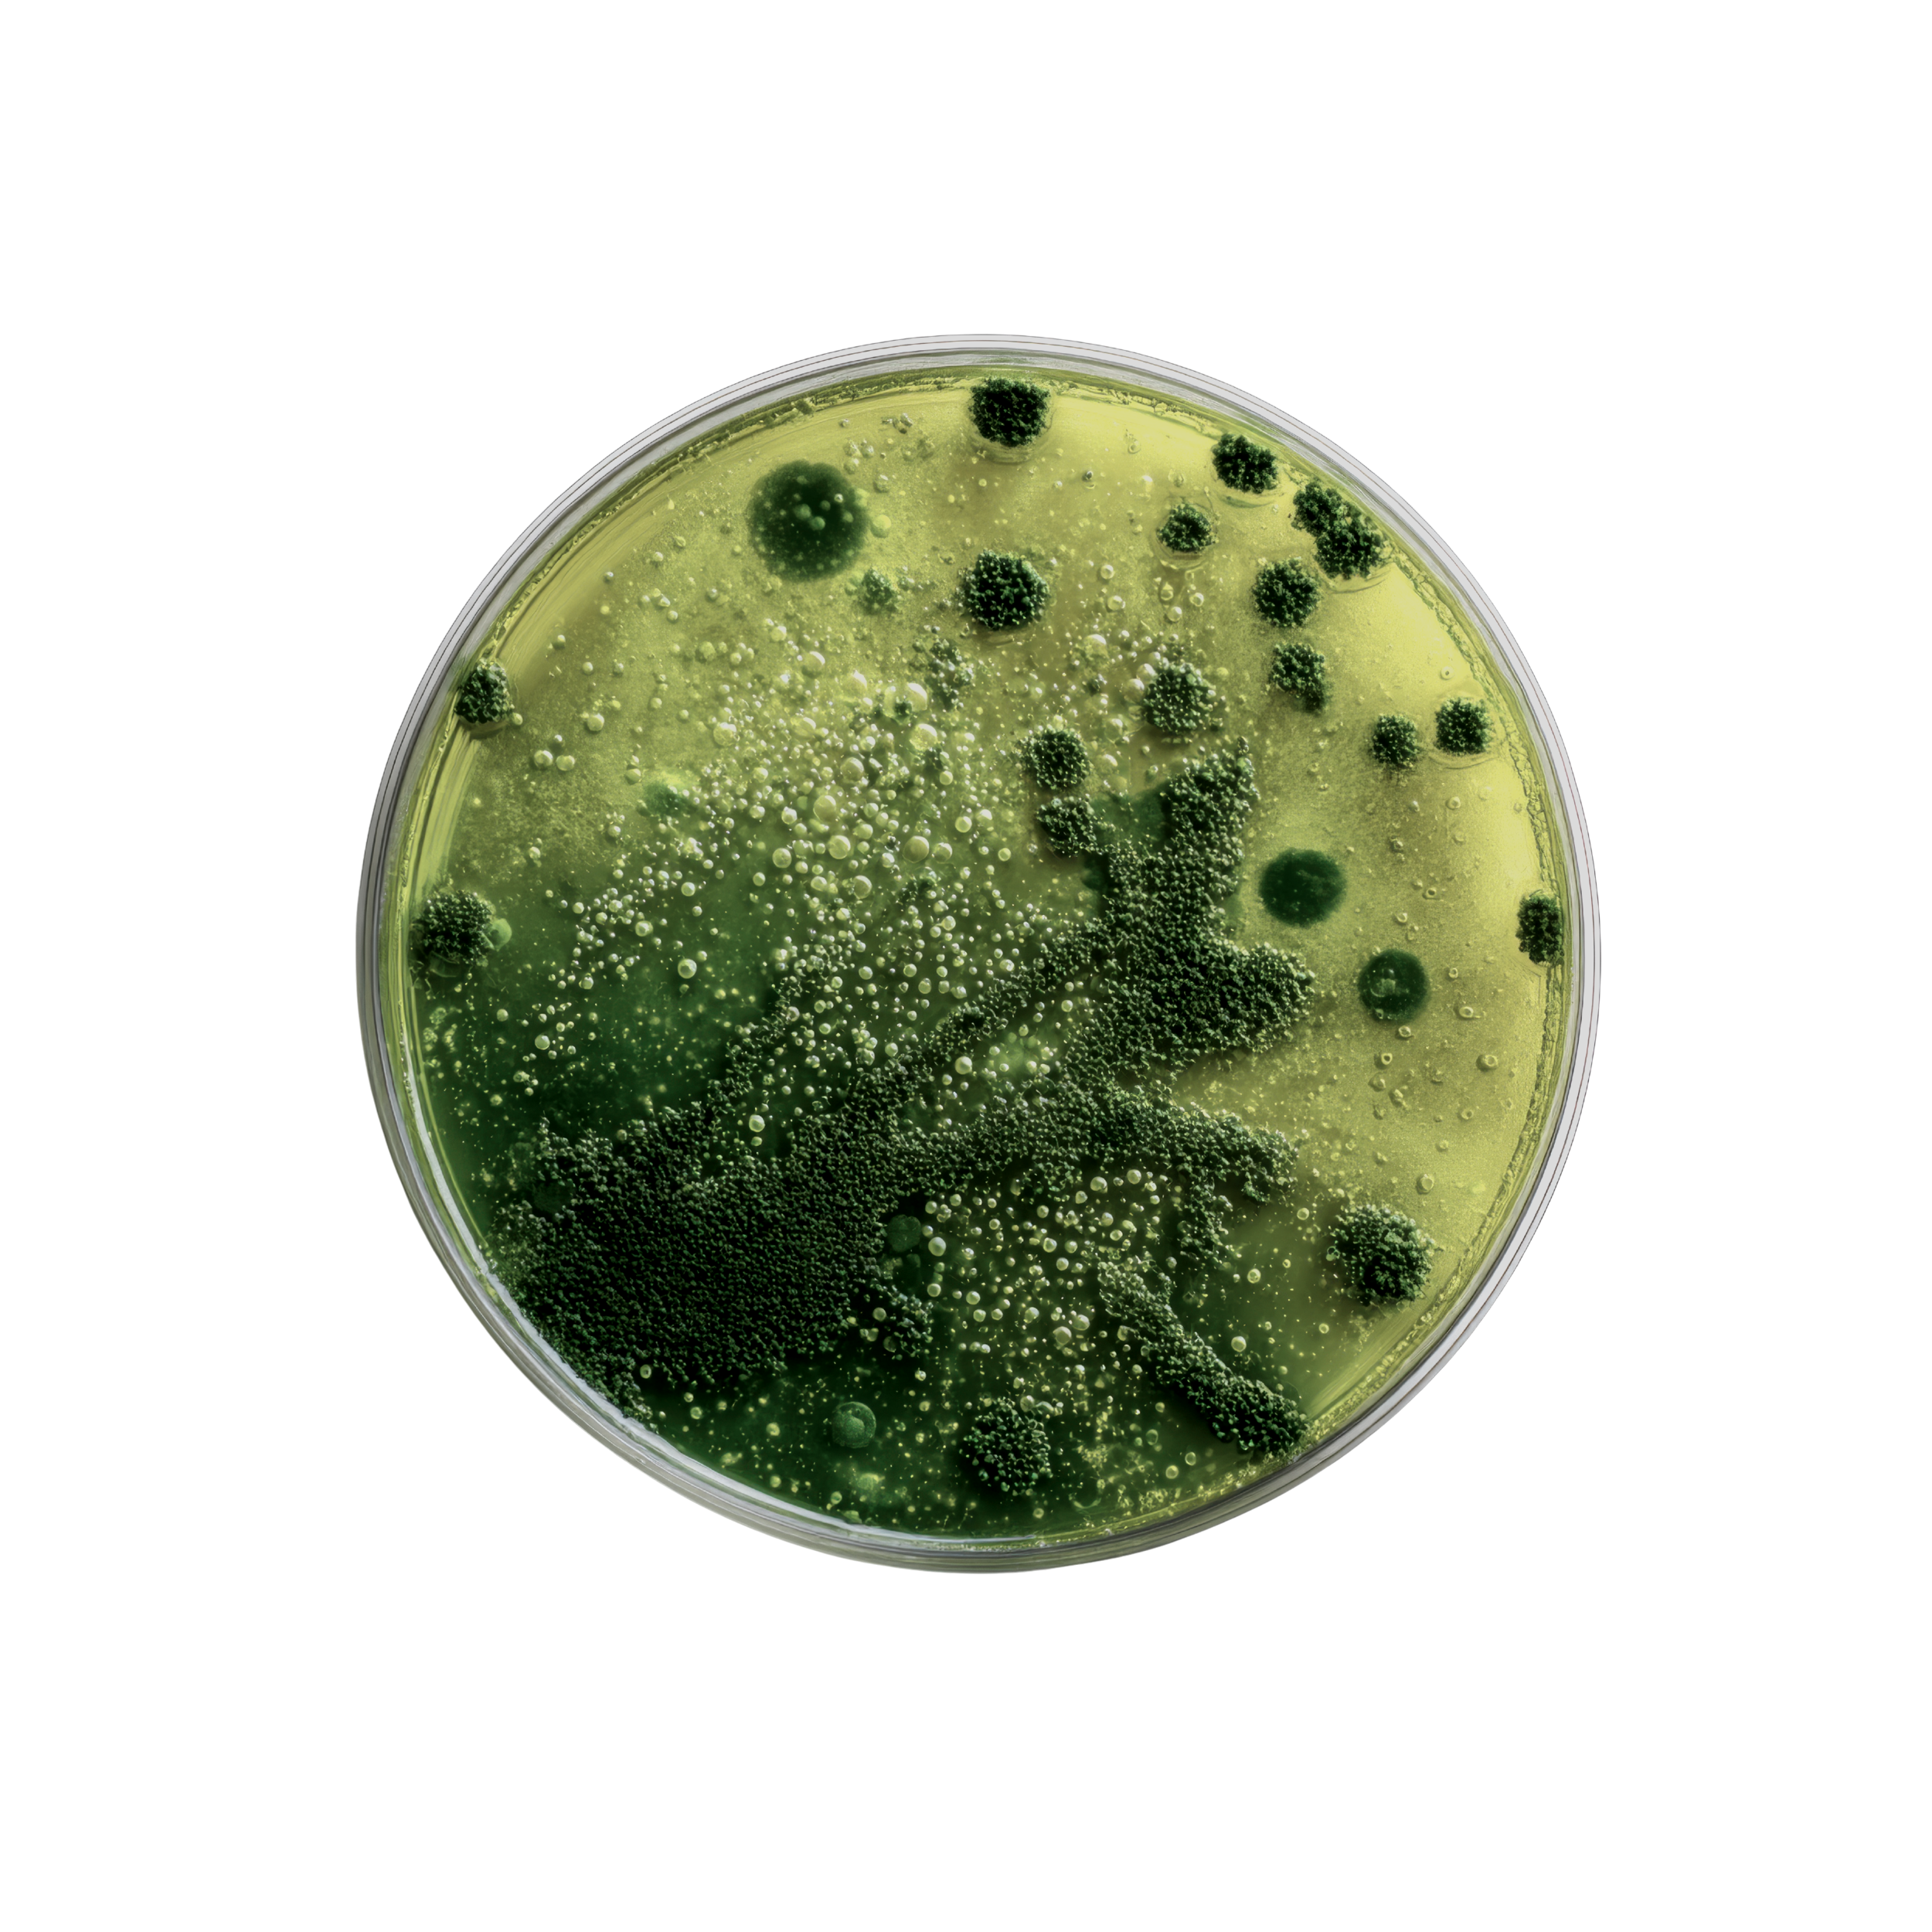

Ocean Health.
Our ocean‑independent ethos.
Marine ecosystems are under increasing pressure globally, and the demand for fish and krill oil continues to strain marine food webs. Our approach to marine nutrients is shaped by a long‑term commitment to supporting these environments.
This page outlines the principles that guide our work and the steps we take to play our part.
Why marine-independent matters
According to the Food and Agriculture Organisation (United Nations, 2025), 35.5% of global marine fish stocks are overfished and 64.5% are harvested at or near their maximum sustainable limit.
Traditional omega‑3 supplements rely on fish or krill oil — industries associated with overfishing and by‑catch. These oils also show considerable variability in contaminants. A 2022 analysis of fish‑oil supplements identified several products with measurable heavy metals, including one sample with more than ten times the accepted lead (Pb) limit.
Omega-3, and many other marine nutrients can be produced responsibly on land, through algae cultivation or synthetic production, resulting in clean, responsible nutrition.

We source a pure, EPA-rich oil from a leading bioscience company headquartered in the Netherlands.
Microalgae are the original source of marine omega‑3s and can be cultivated without extracting from the ocean. Grown in closed bioreactors, they minimise contamination risk and provide a clean alternative to fish oils.
Our ingredient is:
100% ocean‑independent
Produced without fish or krill
Free from ocean pollutants
Rich in EPA — mimicking fish oil
Consistent, clean, and traceable
Algae-Derived Omega-3:
Our Source of
EPA & DHA

Supporting Marine Protected Areas
As part of our commitment, we plan to contribute £1 for every Apozem product purchased to an organisation dedicated to the protection and restoration of marine protected areas. Each omega-3 bottle purchased represents one less bottle of fish oil demanded from the ocean — small but meaningful steps toward reducing pressure on marine habitats.
Once a partnership is established, we will share details of the organisation that we support and provide transparent updates on the progress of this initiative.

Beyond Ingredients: Our Broader Commitment
Our long‑term vision is to:
Further support conservation initiatives
Publish transparent environmental reports from our work
Maintain low-impact packaging and a fully ocean-independent approach
Collaborate with research groups in marine science
References
1. FAO (2025). Review of the State of World Marine Fishery Resources. United Nations Ocean Conference. Nice, France.
2. Ozyurt, G., Ekmen, D., Durmuş, M. et al. (2022) Assessment of the safety of dietary fish oil supplements in terms of content and quality. Environ Sci Pollut Res 29, 25006 – 25019.

